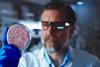
Middle,Aged,Man,Examining,Petri,Dish,With,Lab,Grown,Meat

All Middle East articles – Page 3
-
Podcast
Episode 55: Diving into cultivated fish developments
Food to Go is back and this episode, Grace Galler sits down with Roee Nir, Co-Founder and CEO of Forsea Foods to find out how the company is using groundbreaking cell-cultivation technology, developing sustainable eel unagi, and their plans for market expansion and future innovations.
-
 Article
ArticleA look inside the Forsea seafood experience
Here, Roee Nir explains how Forsea's cultured eel meat offers a sustainable solution to the declining wild eel population, while preserving the culinary tradition of unagi.
-
 Article
ArticleTackling overfishing with cell-cultivated fish
Here, Daphna Heffetz outlines how alternative seafood products could mitigate the impact of overfishing, support sustainable practices, and offer nutritious options for consumers.
-
 Podcast
PodcastEpisode 48: Did COP28 deliver? Part Two with Sam Fulton
Food to Go returns with more analysis of COP28 and its true impact on the food and beverage industry.
-
Article
Will the Suez Canal Crisis drive more food fraud?
Professor Chris Elliott explains why ongoing unrest in the Middle East could impact food security and prices on faraway shores…
-
Podcast
Episode 48: Did COP28 deliver? Part One
In this podcast episode, Josh and Grace speak to Joanna Trewern about whether the recent COP28 conference really delivered for the food sector or if it was merely talking shop.
-
 News
NewsForsea develops its first cultured eel prototype
Israel-based foodtech startup Forsea Foods shares its mission to save wild eel populations through its first prototype of cell-cultivated freshwater eel.
-
 News
NewsAleph Farms makes history as world's first cutlivated beef is approved for sale
The first non-chicken cultivated meat product has recieved a "no questions" letter from the Israeli Ministry of Health.
-
 Article
ArticleWere food systems just a side dish at COP28?
Dr Lucy Wallace reflects on how the COP28 conference resulted in a landmark deal focusing on climate action but may have fallen short when it comes to transforming food systems.
-
 News
NewsLess than half of Brits believe COP28 will lead to “tangible change”
In the fight against climate change, only 38 percent of Brits have said that they believe COP28 will lead to “tangible change”, research finds.
-
 Article
ArticleWas food really on the menu at the first ‘Food COP’?
Joanna Trewern takes you inside COP28 and asks whether, despite all the talk, food really made it onto the menu in Dubai.
-
 Article
ArticleThe meat of the matter: how livestock fared at COP28
Michael Victor reveals the ways in which COP28 prioritised food and agriculture, highlighting crucial links between climate change, farming, and the need for nuanced solutions.
-
 Article
ArticleNew Food Issue 2 2023
Issue 2 2023 of New Food is out now - download your copy today to get more than 60 pages of insight and analysis of the food and beverage industry.
-
 News
NewsSalalah free zone: A business gateway to growth in MENA
Dr. Ali bin Mohammed Tabouk explains the advantages of utilising the Salah Free Zone, located in the Sultanate of Oman.
-
News
NewsUS responsible for 60 percent of global cultivated meat investment
According to a study, the US has broken the “billion dollar barrier", accounting for 60 percent of the global investment in lab-grown meat.
- Previous Page
- Page1
- Page2
- Page3
- Next Page



